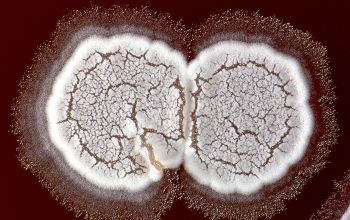

Nocardia astroides
-
General information
Taxonomy
Family: Nocardiaceae
Natural habitats
While the aerobic Actinomycetes are widely distributed in the environment, the extent to which particular species geographically restricted is not well known.
Their primary ecological niche is probably the decomposition of plants material.
Clinical significance
Nocardia infections generally result either from trauma related introduction of the organism or, particularly in immunocompromised patients, from inhalation and the resulting formation of a pulmonary focus.
The most common form of human nocardiosis disease is a slowly progressive pneumonia, the common symptoms of which include cough, dyspnea, and fever.
It is not uncommon for this infection to spread to the pleura or chest wall.
Every organ can be affected if a systemic spread takes place.
They are involved in the process of endocarditis and the infection can take the form of encephalitis and/or brain abscesses.
-
Gram stain
Macroscopic examination
In cases of suspected actinomycetoma, aspirated material should be examined grossly for the presence of granules by spreading the sample in a petri dish.
Granules found should be washed and crushed.
Smears should be prepared from the crushed material, and media should be inoculated.
Granules are most often seen in infections caused by N. brasiliensis, but also can be produced by other Nocardia species.
Gram stain
Gram staining is the most sensitive method by which to visualize and recognize Nocardia in clinial samples.
Clinical specimens
Beaded Gram positive rods,
0.5-1.0, thin,
filamentous and typically right angle branching.
Usually in a background of purulence with many polymorph nuclear leukocytes.
Modified Kinyoun acid fast stain
Use of the modified acid-fast stain with direct clinical samples is unreliable and should be used only to confirm the acid fastness of organisms detected by the Gram stain.
The Nocardia are often seen as partially acid-fast filamentous bacilli (showing both acid-fast and non-acid-fast Nocardia).
This acid fastness may be variable when staining colonies of Nocardia from cultured material.
Colonial acid-fast smear may be related to the type of medium used and the age of the culture, and filaments may fragment into bacilli or coccoid forms.
-
Culture characteristics
-
Obligate aerobic
BA: colonies are chalky, matte or velvety, powdery (usually), irregular, wrinkled, heaped, or smooth on surface; may be brown, tan, pink, orange, red, purple, gray, yellow, peach, or white on reverse; smooth or granular; soluble brown or yellow pigments may be present.
Cultures for Nocardia require a minimum of 48 to 72 h before colonies are evident
Colonial morphology should also be observed macroscopically and microscopically for the presence of aerial hyphae.
The use of a stereoscope will allow early recognition of the aerial hyphae of Nocardia isolates, which will impart a “cotton candy” appearance to the colony surface.
Colonies should be examined for the appearance of the substrate and aerial hyphae.
Although they may be subtle, or may be absent in rare cases, the presence of aerial hyphae will differentiate the genus Nocardia from related genera, including Rhodococcus, Gordonia, Tsukamurella, Corynebacterium and Mycobacterium.
Streptomyces species and other members of the aerobic Actinomycetes may also show aerial hyphae, but these genera will not give a positive result with the modified acid-fast smear.
On slide culture Nocardia will show complex substrate hyphae branching at right angles and usually with secondary branching.
Colonial morphology of the Nocardia is variable, from the smooth, almost bacterium-like appearance of N. farcinica, which turns orange with age, to a more chalky white appearance of most other species, depending on the presence of aerial hyphae.
Isolates of N. brasiliensis typically have a yellowish coloration, and isolates of N. asteroides type VI frequently produce a brown diffusible pigment that is rarely seen with other Nocardia species.
The appearance may also differ depending upon the medium or incubation temperature. Nocardia grow readily on most nonselective laboratory media, but colonies may take from 2 to 14 days to appear.
Therefore, plates should be held for at least 2 weeks prior to being discarded and should be incubated in a humidified environment or sealed to prevent dehydration. Heavy growth of other bacterial species may therefore obscure the presence of the Nocardia on routine culture plates that may be discarded before the Nocardia colonies are detected.
Selective media may be necessary to enhance recovery of Nocardia species and minimize the growth of contaminating organisms, such as BCYE (Buffered Charcoal Yeast agar)
BBAØ no growth
Smell moldy basement
-
-
Characteristics
-
References
James Versalovic et al.(2011) Manual of Clinical Microbiology 10th Edition
Karen C. Carrol et al (2019) Manual of Clinical Microbiology, 12th Edition
Clin Microbiol Rev. 2006 Apr; 19(2): 259–282. Clinical and Laboratory Features of the Nocardia spp. Based on Current Molecular Taxonomy Barbara A. Brown-Elliott,1 June M. Brown,2 Patricia S. Conville,3 and Richard J. Wallace, Jr1,*